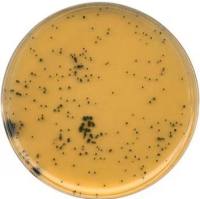
1.11972.0500 Merck 默克 GranuCult® 胰月示亚硫酸盐环丝氨酸琼脂（基础）

相关产品推荐更多 >
万千商家帮你免费找货
0 人在求购买到急需产品
- 详细信息
- 文献和实验
- 技术资料
- 库存:
999
- 保修期:
可咨询
- 现货状态:
可咨询
- 供应商:
默克
- 规格:
1.00205.0500
一般描述
GranuCult®prime MacConkey(MAC)琼脂是一种选择性琼脂培养基,用于从食品链、化妆品、药品和其他材料中分离和确认大肠杆菌和其他肠杆菌科,如沙门氏菌和志贺菌。这种培养基含有结晶紫和胆汁盐,它们抑制革兰氏阳性微生物菌群的生长,同时允许革兰氏阴性细菌生长。蛋白胨提供氮、维生素和氨基酸。乳糖和pH指示剂中性红用于检测乳糖降解。乳糖的发酵导致pH值局部下降,导致pH指示剂呈中性红色。由此形成红 粉色菌落,菌落周围的培养基颜色变为红色。通常在菌落周围形成胆汁沉淀区。胆汁盐和结晶紫抑制革兰氏阳性菌的生长。琼脂是固化剂。
应用
GranuCult®prime MacConkey(MAC)琼脂用于从食品链、化妆品、药品和其他材料中分离和确认大肠杆菌和其他肠杆菌科,如沙门氏菌和志贺菌。样品中有多种细菌,如沙门氏菌、志贺菌和大肠杆菌。

风险提示:丁香通仅作为第三方平台,为商家信息发布提供平台空间。用户咨询产品时请注意保护个人信息及财产安全,合理判断,谨慎选购商品,商家和用户对交易行为负责。对于医疗器械类产品,请先查证核实企业经营资质和医疗器械产品注册证情况。
文献和实验相关专题 德国默克是世界上历史最悠久的化学制药公司之一。已有335年历史的默克公司于1998年收购了美国CN Bioscience集团(包括Calbiochem,Oncogene,Novabiochem和Novagen四大品牌),CN Bioscience(现已改名为MERCK Bioscience)的四大品牌分别在生化、信号传导、蛋白质化学和分子生物学领域内均以创新而优质的产品著称。另外,默克生化小组(中国)还独家代理了以其优质
用于进一步分析。 总部设在美国西雅图的Amnis公司开发、制造并推广高速细胞成像系统,用于科研和诊断市场。去年,Amnis公司被默克密理博(Merck Millipore )收购,以补充其Guava流式细胞仪产品线。
Western Blot、ELISA等实验是目前实验室最常用的检测蛋白量的实验方法。然而许多研究人员都会在这些实验过程中遇到背景过高或信号太弱等问题,影响了结果分析和实验进度。如何更好地解决实验中遇到的这些问题?许多研究者花费了大量的时间和经费优化实验条件以求得到更好的结果,结果却往往差强人意。 为了更好地解决这个虽然很小,却困扰很大的问题--低信号/高背景,德国默克公司经验丰富的研发团队经过不断摸索开发出了SignalBoostTM 免疫信号增强试剂盒(货号:407207)。该试剂盒是一种
技术资料暂无技术资料 索取技术资料